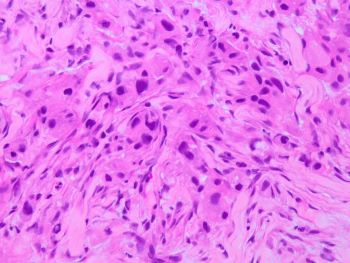
salivary duct ca HE 40x

Case History
A 67-year-old male presents with a parotid mass associated with facial pain and cervical adenopathy. Fine-needle aspiration and core needle biopsy are performed and representative sections are shown.p63 immunostain is negative.
Which stain is expected to be diffusely positive?
- SOX10
- Androgen receptor
- p40
- Calponin

Correct Answer: B. Androgen receptor
Discussion:
Brief explanation of the answer: The cytology smears show cells with oncocytic morphology and significant nuclear atypia. Histologic sections show pleomorphic tumor cells infiltrating as cords and nests. No keratinization or mucinous cells are noted. Salivary duct carcinoma is an important diagnostic consideration when encountering atypical oncocytic cells. This aggressive tumor typically affects older males and is associated with a poor prognosis. Tumor cells are positive for androgen receptor and GATA-3 and negative for myoepithelial markers. Some cases may also express Her2 by immunohistochemistry.